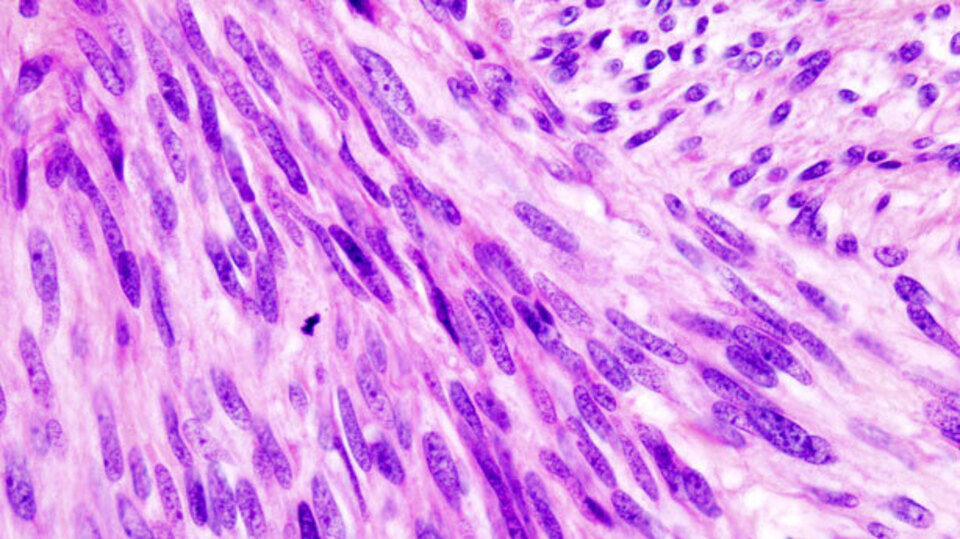

Nueva indicación para Lynparza en cáncer de páncreas metastásico
La FDA norteamericana añade un nuevo uso para este inhibidor de PARP, que ya tiene autorizaciones para cáncer de ovario y mama.
AstraZeneca y MSD han recibido el visto bueno de la agencia reguladora estadounidense FDA para una nueva indicación de Lynparza olaparib- como tratamiento de mantenimiento en pacientes adultos con cáncer de páncreas metastásico con mutación o sospecha de mutación de BRCA, en los que la enfermedad no ha progresado durante al menos 16 semanas de tratamiento quimioterápico en primera línea. Los pacientes candidatos a este tratamiento se podrán determinar gracias a un test diagnóstico específico para Lynparza, también aprobado por la FDA.
La aprobación se ha basado en los resultados del ensayo pivotal en fase III POLO, publicado en The New England Journal of Medicine y presentado en el congreso anual de la Sociedad Americana de Oncología Clínica (ASCO) de 2019.
Los resultados del estudio demostraron una mejora estadística y clínicamente significtiva de la supervivencia libre de progresión, de manera que los pacientes en tratamiento con Lynparza casi duplicaron en supervivencia libre de progresion a los que no recibieron el tratamiento.
Lynparza es un inhibidor de PARP, primero de clase, y el primer medicamento dirigido a bloquear la respuesta de ADN dañado en células tumourales portadoras de una deficiencia en la reparación de la recombinación homóloga (HRR), como las mutaciones en BRCA1 y/o BRCA2.
El medicamento dispone ya de varias autorizaciones y otras indicaciones en evaluación. De momento, está aprobado en 65 países, incluidos los de la Unión Europea, para el tratamiento de mantenimiento del cáncer de ovario refractario sensible a platino con independencia del estatus de BRCA. También está aprobado en Estados Unidos, la UE, Japón, China y varios otros como tratamiento de primera línea del cáncer de ovario avanzado con mutación de BRCA tras respuesta a quimioterapia basada en platino. En 44 países está autorizado, asímismo, en cáncer de mama metastásico con mutación de BRCA y HER2-negativo, tratado previamente con quimioterapia.